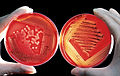

Category:Featured pictures on Wikipedia, Turkish
Jump to navigation
Jump to search
Subcategories
This category has only the following subcategory.
Media in category "Featured pictures on Wikipedia, Turkish"
The following 200 files are in this category, out of 1,766 total.
(previous page) (next page)- "Colored" drinking fountain from mid-20th century with african-american drinking.jpg 5,276 × 3,618; 5.37 MB
- "The School of Athens" by Raffaello Sanzio da Urbino.jpg 3,820 × 2,964; 2.35 MB
- 011218-N-9769P-047 F-A-18 With Weapons Ready for Mission.jpg 2,000 × 1,312; 1.33 MB
- 04-09-12-Schaupflügen-Fahrenwalde-RalfR-IMG 1232.jpg 1,600 × 1,200; 1.2 MB
- 07. Camel Profile, near Silverton, NSW, 07.07.2007.jpg 1,300 × 1,600; 1.41 MB
- 122 - Toronto - Septembre 2009.jpg 16,700 × 4,478; 31.74 MB
- 1783 balloonj.jpg 2,717 × 3,701; 13.66 MB
- 1882 Kingston Fire.png 3,800 × 5,050; 8.49 MB
- 1902 Wright Brothers' Glider Tests - GPN-2002-000125.jpg 2,396 × 1,670; 607 KB
- 1944 NormandyLST.jpg 3,000 × 2,274; 383 KB
- 1997 F-4 Heritage Flight over Florida-edit 1.jpg 2,496 × 1,611; 833 KB
- 1axc tricolor.png 1,108 × 1,196; 582 KB
- 1Mcolors.png 1,000 × 1,000; 6 KB
- 2003 Mazda6 GG Classic Hatch, McMillans Lookout, Vic, 21.12.2008.jpg 5,640 × 3,040; 4.21 MB
- 2004 Indonesia Tsunami Complete.gif 300 × 276; 1.1 MB
- 2006 Ojiya balloon festival 011.jpg 1,896 × 2,852; 1.81 MB
- 2006-02-13 Drop-impact.jpg 1,556 × 1,504; 1.44 MB
- 2006-02-15 Piping.jpg 2,592 × 1,944; 2.01 MB
- 20070818-0001-strolling reindeer.jpg 2,482 × 1,650; 1.2 MB
- 2008 South Ossetia war tr.svg 1,940 × 1,370; 2.37 MB
- 2010-kodiak-bear-1.jpg 2,400 × 1,600; 871 KB
- 20110419 Ani North Walls Turkey Panorama.jpg 13,000 × 1,486; 16.72 MB
- 2012-bb-jackal-1.jpg 4,000 × 2,666; 5.75 MB
- 20120604 Edirne view from the top of the Minaret of Selimiye Mosque Edirne Turkey Panoramic.jpg 12,053 × 1,951; 19.8 MB
- 2013-08-07 04-23-26-foudre-belfort.jpg 4,288 × 2,566; 8.71 MB
- 20151030 Syrians and Iraq refugees arrive at Skala Sykamias Lesvos Greece 2.jpg 5,000 × 3,337; 5.76 MB
- 236084main MilkyWay-full-annotated tr.jpg 5,600 × 5,600; 9.19 MB
- 333 Cappadocia1.jpg 4,928 × 3,264; 22.82 MB
- 3rd Battalion, 3rd Marines - Afghanistan.jpg 3,072 × 2,048; 1.73 MB
- 4-14 Marines in Fallujah.jpg 3,072 × 2,048; 2.18 MB
- 433eros.jpg 1,024 × 691; 68 KB
- 442 regimental combat team.jpg 2,736 × 2,218; 839 KB
- 4th FW Strike Eagles assist shuttle launch.jpg 1,724 × 2,100; 2.09 MB
- 5-54-Mark-45-firing edit.jpg 1,400 × 1,000; 460 KB
- 79 - Québec - Juin 2009.jpg 15,262 × 3,628; 22.58 MB
- 790106-0203 Voyager 58M to 31M reduced.gif 390 × 400; 2.96 MB
- 80 - Machu Picchu - Juin 2009 - edit.jpg 10,000 × 9,760; 76.62 MB
- 99 - Machu Picchu - Juin 2009.edit3.jpg 9,187 × 4,100; 29.59 MB
- A couple of Tadorna ferruginea.jpg 2,223 × 3,160; 5.81 MB
- A day panorama - digital art.jpg 5,530 × 954; 1.04 MB
- A Minatarre chief 0057v edit.jpg 2,848 × 4,080; 7.06 MB
- A painting in Chehel Sotoun1.jpg 1,612 × 1,726; 3.44 MB
- A single white feather closeup.jpg 1,024 × 1,365; 175 KB
- A smoky day at the Sugar Bowl--Hupa.jpg 1,476 × 2,000; 1.14 MB
- A Su-27 escorted by an F-16.jpg 2,820 × 1,890; 1.97 MB
- A Swift's Call To Prayer.jpg 2,247 × 3,383; 8.62 MB
- A Wilde time 3.jpg 3,615 × 2,471; 9.19 MB
- A-20 Havoc.jpg 7,157 × 5,561; 3.47 MB
- A380 F-WWEA LEGT 2.jpg 2,534 × 1,319; 1.01 MB
- Ab food 04.jpg 2,048 × 1,536; 680 KB
- Abbasid Koran folio from Egypt.jpg 2,148 × 1,644; 1.1 MB
- Abdullah frères - Sulemaniye camii, Istanbul.jpg 1,129 × 824; 251 KB
- Abdullah frères - Sultan Ahmet camii, Istanbul.jpg 1,035 × 835; 201 KB
- Abies koreana (szyszki).JPG 2,576 × 1,932; 1.95 MB
- Abolish child slavery.jpg 2,811 × 1,919; 4.7 MB
- Abraham Lincoln head on shoulders photo portrait.jpg 2,850 × 3,742; 2.68 MB
- Accnis edit.jpg 1,717 × 1,596; 1.53 MB
- Achelousaurus dinosaur.png 1,284 × 1,280; 2.16 MB
- Actitis hypoleucos.jpg 1,920 × 1,078; 367 KB
- Ada Lovelace portrait.jpg 2,439 × 3,504; 2.19 MB
- Adams The Tetons and the Snake River.jpg 3,000 × 2,402; 1.78 MB
- Adana Garı(Gece).jpg 3,000 × 1,370; 1,022 KB
- Adansonia grandidieri04.jpg 1,944 × 2,592; 1.2 MB
- Aepyceros melampus petersi female 8014.jpg 5,616 × 3,744; 9.54 MB
- Aeroflot Airbus A330 Kustov edit.jpg 3,636 × 2,000; 3.38 MB
- Aerogelbrick.jpg 752 × 794; 445 KB
- Aeronautics2.jpg 3,872 × 4,877; 13.32 MB
- Aeropuerto Internacional de Tallinn, Estonia, 2012-08-05, DD 03.JPG 3,157 × 2,130; 1.61 MB
- Aesculus hippocastanum fruit.jpg 1,024 × 768; 400 KB
- Aeshna cyanea - head close-up (aka).jpg 1,304 × 1,285; 553 KB
- Afghanistan Statua di Budda 1.jpg 577 × 850; 110 KB
- African boy transporting fodder by bicycle edit.jpg 1,800 × 1,200; 1.5 MB
- African Buffalo.JPG 2,296 × 1,722; 918 KB
- African Lion Panthera leo Male Pittsburgh 2800px adjusted.jpg 2,800 × 2,000; 2.17 MB
- After the war a medal and maybe a job2.jpg 5,042 × 3,355; 12.22 MB
- Agarplate redbloodcells edit.jpg 2,000 × 1,268; 905 KB
- Agassiz statue Mwc00715.jpg 2,087 × 1,479; 434 KB
- Ahu Tongariki cropped.jpg 2,256 × 1,500; 2.14 MB
- Ahu Tongariki.jpg 3,008 × 2,000; 723 KB
- Aichi Val DF-ST-91-10602.JPEG 2,860 × 1,880; 1.71 MB
- Aida poster colors fixed.jpg 4,780 × 2,988; 8.74 MB
- Air Force One over Mt. Rushmore.jpg 1,900 × 1,528; 1.72 MB
- Airplane vortex edit.jpg 2,976 × 2,420; 995 KB
- Akal Takht and Harmandir Sahib, Amritsar, Punjab, India.jpg 3,637 × 2,117; 1.69 MB
- Alamo pano.jpg 9,214 × 4,157; 11.04 MB
- Alaska Purchase (hi-res).jpg 3,135 × 1,548; 4.42 MB
- Albi panorama morning Wikimedia Commons.jpg 15,160 × 3,695; 12.08 MB
- Albino Macropus rufogriseus rufogriseus.jpg 1,296 × 1,944; 868 KB
- Alcatraz Cellhouse.jpg 1,289 × 396; 231 KB
- Alcatraz03182006.jpg 4,024 × 624; 652 KB
- Aldrin Apollo 11.jpg 2,700 × 2,700; 2.44 MB
- AlfredPalmerM3tank1942b.jpg 3,000 × 2,200; 3.86 MB
- AlfredPalmerwelder1.jpg 2,000 × 1,519; 1.07 MB
- Alhambra wall detail.jpg 2,479 × 1,648; 748 KB
- Alhambra2001.jpg 2,600 × 565; 441 KB
- Alitalia md-82 i-dacz planform arp.jpg 2,400 × 1,600; 1.14 MB
- All Gizah Pyramids.jpg 4,372 × 2,906; 5.78 MB
- Allende supporters.jpg 3,708 × 2,459; 1.12 MB
- Allianz arena at night Richard Bartz.jpg 5,000 × 1,786; 3.99 MB
- Allianz arena daylight Richard Bartz.jpg 5,000 × 2,061; 5.43 MB
- Allianz arena golden hour Richard Bartz.jpg 5,000 × 1,676; 3.35 MB
- Allium 'Lucy Ball' Pink Flower Head 2236px.jpg 2,236 × 1,935; 1.96 MB
- Alone at last2.jpg 2,280 × 2,620; 5.5 MB
- Alpamayo.jpg 2,272 × 1,704; 1.43 MB
- Alpinistes Aiguille du Midi 03.JPG 2,592 × 2,978; 1.6 MB
- Alter Strom.jpg 1,600 × 1,067; 517 KB
- Altes Rathaus Bonn.jpg 6,064 × 5,466; 9.9 MB
- Aluminium bar surface etched.jpg 5,616 × 3,744; 22.99 MB
- Amadina erythrocephala ♂.jpg 1,750 × 1,312; 1.78 MB
- Amanite tue-mouche.JPG 2,048 × 1,536; 653 KB
- Ambersweet oranges.jpg 1,999 × 2,254; 1.41 MB
- American bison k5680-1.jpg 2,700 × 1,761; 1.32 MB
- American World War II senior military officials, 1945.JPEG 2,837 × 2,264; 1.21 MB
- Amethyst. Magaliesburg, South Africa.jpg 2,016 × 1,344; 1.06 MB
- Amiga500 system.jpg 2,531 × 1,965; 2.16 MB
- Amstel.jpg 8,000 × 3,041; 19.2 MB
- AmstelHotelAmsterdam.jpg 5,554 × 2,941; 8.73 MB
- Amsterdam Canals - July 2006.jpg 4,017 × 2,117; 3.69 MB
- Amsterdam photochrom2.jpg 3,288 × 2,396; 6.97 MB
- Amundsen-Scott marsstation ray h edit.jpg 3,072 × 2,048; 1.85 MB
- Amur Leopard Pittsburgh Zoo.jpg 2,979 × 1,600; 1.99 MB
- An Ant in Colombian amber.jpg 1,777 × 1,682; 1.87 MB
- An elderly Tibetan women holding a prayer wheel on Lhasa, Barkhor.jpg 2,000 × 1,333; 570 KB
- Anas platyrhynchos male female quadrat.jpg 2,384 × 2,384; 4.54 MB
- Anas-strepera-001.jpg 1,536 × 1,024; 457 KB
- Andean Flamingos Laguna Colorada Bolivia Luca Galuzzi 2006.jpg 2,000 × 1,333; 1.04 MB
- Andean Man.jpg 1,806 × 2,400; 2.75 MB
- Andreas Waldherr Lavanttal Rallye 2009 2.jpg 3,614 × 2,256; 1.32 MB
- Andromeda Galaxy (with h-alpha).jpg 3,000 × 1,971; 4.89 MB
- Andromeda galaxy Ssc2005-20a1.jpg 8,193 × 2,410; 21.19 MB
- Angela Merkel (2008).jpg 2,666 × 2,000; 2.11 MB
- Animal cell structure tr.svg 600 × 420; 148 KB
- Animated gun turret with labels.gif 685 × 599; 117 KB
- Anime Girl.svg 1,052 × 744; 626 KB
- AnnapolisGraduation.jpg 3,008 × 2,000; 1.75 MB
- Anse Source d'Argent 2-La Digue.jpg 2,000 × 1,435; 2.15 MB
- Ansel Adams - Farm workers and Mt. Williamson.jpg 2,000 × 1,500; 1.54 MB
- Antarctica 6400px from Blue Marble.jpg 6,400 × 6,400; 3.31 MB
- Antennae galaxies xl.jpg 3,915 × 3,885; 14.64 MB
- Antep 1250575b.jpg 2,547 × 1,658; 3.95 MB
- Anthurium scherzerianum 2.jpg 1,944 × 1,296; 1.49 MB
- Antik Mısır haritası.png 1,577 × 3,219; 307 KB
- Anvil shaped cumulus panorama edit crop.jpg 2,348 × 965; 477 KB
- Anzer yaylası-2.JPG 3,008 × 2,000; 2.88 MB
- Apikal4D.gif 636 × 432; 705 KB
- Apis mellifera carnica worker hive entrance 3.jpg 4,000 × 2,400; 3.89 MB
- Apis mellifera flying.jpg 1,754 × 1,169; 514 KB
- Apollo 11 bootprint.jpg 2,349 × 2,363; 2.41 MB
- Apollo 11 Launch2.jpg 2,400 × 3,000; 8.2 MB
- Apollo 11 Lunar Lander - 5927 NASA.jpg 2,349 × 2,362; 856 KB
- Apollo 15 flag, rover, LM, Irwin.jpg 2,400 × 2,400; 1.29 MB
- Apollo 17 Cernan on moon.jpg 3,904 × 4,029; 2.61 MB
- Apollo 17 Moon Panorama.jpg 16,810 × 1,708; 12.81 MB
- Apollo13-load on deck crop1.jpg 4,064 × 3,880; 2.85 MB
- Apricot and cross section.jpg 1,910 × 989; 373 KB
- Apricots Drying In Cappadocia.JPG 3,456 × 2,592; 4.06 MB
- Aquifer tr.svg 720 × 700; 178 KB
- Ara ararauna Luc Viatour.jpg 2,936 × 2,267; 2.86 MB
- Aralsee tr.gif 560 × 819; 279 KB
- Arc Triomphe.jpg 3,929 × 4,260; 5.91 MB
- Archangel reindeer3.jpg 3,214 × 2,327; 6.09 MB
- Ardea alba4.jpg 1,184 × 1,800; 413 KB
- Arecibo message.svg 512 × 1,536; 3 KB
- Arkansas State Capitol.jpg 9,235 × 3,708; 8.39 MB
- Armenian Patriarch of Jerusalem 1900.jpg 5,058 × 6,244; 10.94 MB
- Arnold Boecklin - Island of the Dead, Third Version.JPG 2,545 × 1,400; 740 KB
- AS8-13-2329.jpg 2,457 × 2,411; 626 KB
- Ase o fuku onna2.jpg 6,079 × 9,236; 44.7 MB
- Assembling B-25 bombers at North American Aviation, Kansas City, Kansas.jpg 7,068 × 5,435; 3.17 MB
- Assortment of Hepaticae from Kunstformen der Natur (1904), plate 82.jpg 2,378 × 3,331; 1.42 MB
- Asteracea poster 3.jpg 3,800 × 5,000; 6.3 MB
- Astronotus ocellatus.jpg 3,457 × 2,304; 4.7 MB
- Ataturk's Mausoleum (6225341313).jpg 5,184 × 3,456; 1.69 MB
- Atatürk TBMM'den çıkarken.jpg 3,303 × 2,339; 1.56 MB
- Atatürk Tokat'ta bir vatandaşı dinliyor (1930).jpg 1,556 × 1,080; 242 KB
- Athanasios Karantz(ou)las - Sultan Mahmud II - Google Art Project.jpg 1,886 × 3,938; 3.04 MB
- Atomic cloud over Hiroshima.jpg 2,491 × 2,937; 2.44 MB
- Atrial septal defect-tr.png 730 × 550; 159 KB
- Attack on carrier USS Franklin 19 March 1945.jpg 2,955 × 2,201; 3.45 MB
- Au Clair de la Lune children's book 2.jpg 1,076 × 948; 1 MB
- Aubrey Beardsley - Edgar Poe 2.jpg 1,292 × 1,998; 391 KB
- AucklandPano MC.jpg 15,000 × 2,271; 8.74 MB
- August Macke 037.jpg 2,024 × 2,961; 1.11 MB
- Aurelia aurita (aka).jpg 2,800 × 2,118; 1.31 MB
- Australia Cairns 01.jpg 1,228 × 1,638; 776 KB
- Australia satellite plane.jpg 5,250 × 4,320; 1.76 MB
- Australian camps on slopes of Olivet & Mount Scopus3.jpg 2,406 × 1,038; 2.28 MB
- Australian cart.jpg 1,600 × 1,200; 524 KB
- Australian infantry small box respirators Ypres 1917.jpg 1,200 × 1,607; 591 KB
- Australian pelican in flight.jpg 1,067 × 1,600; 267 KB
- Auto wreck, USA, 1923.jpg 4,564 × 3,712; 4.43 MB
- Autumn leaves, Talcott Mountain State Park.jpg 3,000 × 2,000; 2.9 MB
- Autumn Red peaches.jpg 2,784 × 1,896; 1.01 MB
- Axis axis (Nagarhole, 2010).jpg 3,200 × 2,134; 6.56 MB
- Aythya fuligula Hires.jpg 2,600 × 1,581; 2.15 MB
- B'nai B'rith membership certificate 1876.jpg 2,450 × 3,081; 3.82 MB
- B-17 group in formation.jpg 1,800 × 1,294; 829 KB
- B-1B over the pacific ocean.jpg 2,000 × 1,328; 457 KB
- B-2 Spirit (cropped).jpg 1,937 × 995; 978 KB
















































.JPG/120px-Abies_koreana_(szyszki).jpg)







.jpg/120px-Adana_Gar%c4%b1(Gece).jpg)







.jpg/120px-Aeshna_cyanea_-_head_close-up_(aka).jpg)

.jpg/120px-Alaska_Purchase_(hi-res).jpg)



































.jpg/120px-Andromeda_Galaxy_(with_h-alpha).jpg)
.jpg/120px-Angela_Merkel_(2008).jpg)


































%2c_plate_82.jpg/86px-Assortment_of_Hepaticae_from_Kunstformen_der_Natur_(1904)%2c_plate_82.jpg)


.jpg/120px-Ataturk%27s_Mausoleum_(6225341313).jpg)

.jpg/120px-Atat%c3%bcrk_Tokat%27ta_bir_vatanda%c5%9f%c4%b1_dinliyor_(1930).jpg)
las_-_Sultan_Mahmud_II_-_Google_Art_Project.jpg/57px-Athanasios_Karantz(ou)las_-_Sultan_Mahmud_II_-_Google_Art_Project.jpg)






.jpg/120px-Aurelia_aurita_(aka).jpg)









.jpg/120px-Axis_axis_(Nagarhole%2c_2010).jpg)




.jpg/120px-B-2_Spirit_(cropped).jpg)